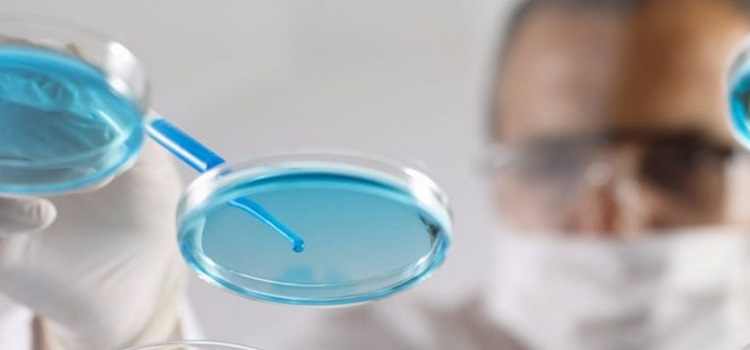

Neocase Software raises €6m for its HR management and automation platform

Thanks to software that facilitates work in the¬†human resources department¬†, the goal of Neocase Software…
Ben (Reactive)19/05/2020